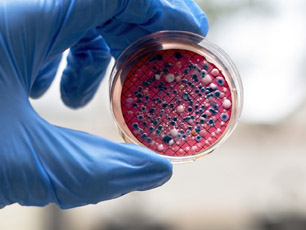

In response to the increasing problem of water shortage, treated urban wastewater is currently widely reused, considered to be a reliable alternative water source. Regions inhabited by more than 40% of the world's population already are in the situation where water demand exceeds supply. The ever-increasing shortage of water, the increasing needs for food due to the expanding world population, and for irrigation water, both in respect to good quality and quantity, render reuse a 'sine qua non' condition. Currently, sustainable and safe urban water cycles are of high priority on the policy agendas of many European countries and elsewhere.
The main objective of ANSWER Project is to develop well-trained and scientifically-creative Early-Stage Researchers (ESRs) through innovative PhD projects to unravel the highly complex factors driving antibiotics and antibiotic-resistant bacteria and antibiotic resistance genes (A&ARB&ARG) propagation in the framework of urban wastewater reuse, in order to assess the relevant environmental/public health risks, able to face current and future challenges and to convert knowledge and ideas into products and services for economic and social benefit.
The ANSWER projects expected to have a major impact on the enhancement of sustainable wastewater reuse at technological, economical and societal level.